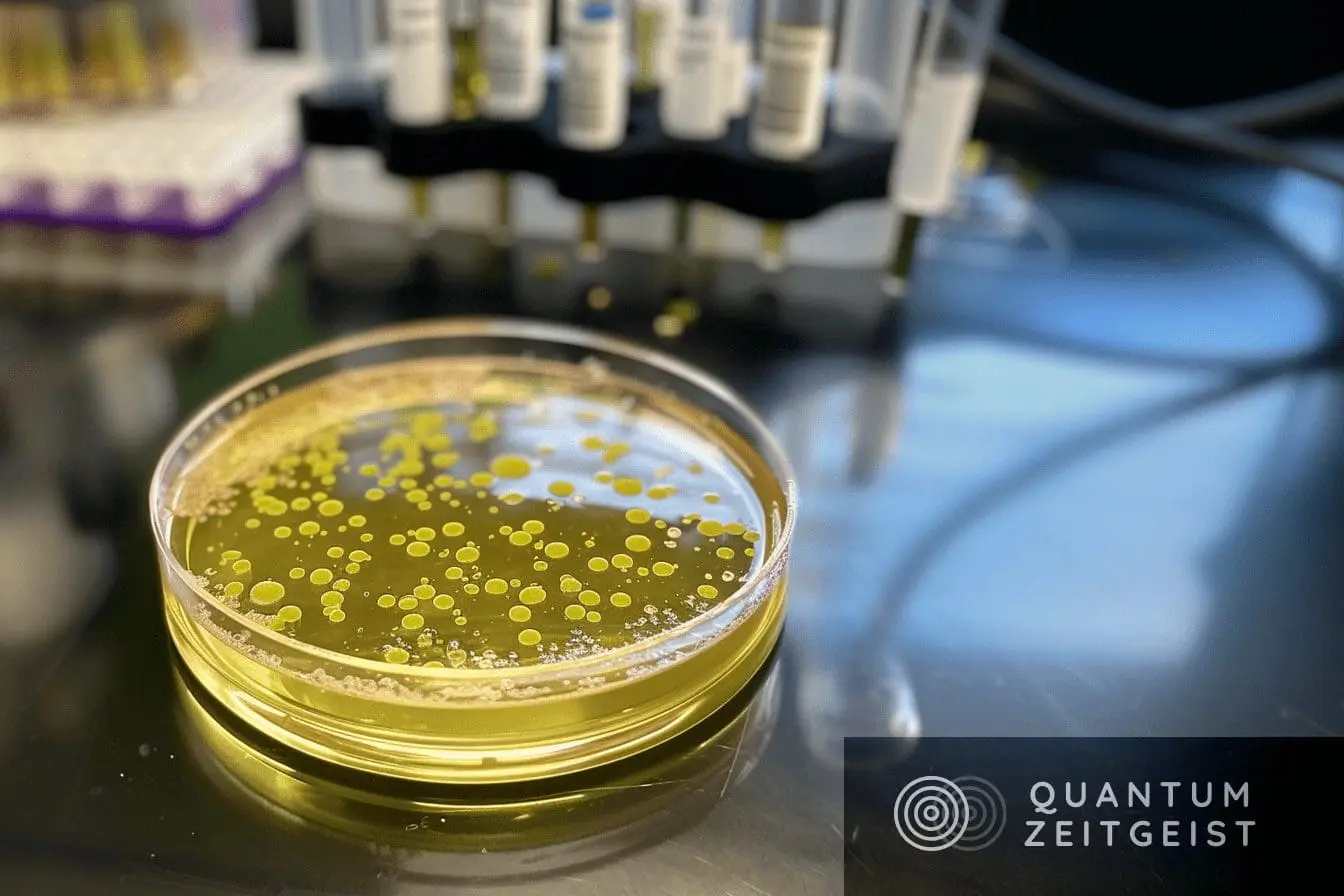
Researchers Develop Paper-Based Fluorescence Sensor for Rapid Bacterial Identification

Researchers from Hefei University of Technology, the National University of Singapore, and The Hong Kong Polytechnic University have developed a paper-based fluorescence sensor array platform for rapid bacterial discrimination. The sensor array uses three unique carbon quantum dots (CQDs) as sensing units, each modified with a different antibiotic. The CQDs aggregate on the bacterial surface, triggering fluorescence quenching. The sensor array exhibits varying fluorescent responses to different bacterial species. The platform’s responses are collected via a smartphone and diverse machine learning algorithms are used to discriminate bacterial types. This method offers a cost-effective, portable solution for on-site detection of diverse bacteria.
What is the New Trend in Bacterial Discrimination?
The rapid discrimination of bacteria is an emerging trend in the fields of food safety, medical detection, and environmental observation. Traditional methods often require lengthy culturing processes, specialized analytical equipment, and bacterial recognition receptors. However, a team of researchers led by Fangbin Wang and Minghui Xiao from the School of Food and Biological Engineering at Hefei University of Technology, Jing Qi from the Department of Chemistry at the National University of Singapore, and Liang Zhu from the Department of Biomedical Engineering at The Hong Kong Polytechnic University have developed a paper-based fluorescence sensor array platform for identifying different bacteria.
The sensor array is based on three unique carbon quantum dots (CQDs) as sensing units, each modified with a different antibiotic: polymyxin B, ampicillin, and gentamicin. These antibiotic-modified CQDs can aggregate on the bacterial surface, triggering aggregation-induced fluorescence quenching. The sensor array exhibits varying fluorescent responses to different bacterial species. To achieve low-cost and portable detection, CQDs were formulated into fluorescent ink and used with an inkjet printer to manufacture paper-based sensor arrays.
How Does the New Bacterial Discrimination Method Work?
A smartphone was used to collect the responses generated by the bacteria and platform. Diverse machine learning algorithms were utilized to discriminate bacterial types. The researchers’ findings showcase the platform’s remarkable capability to differentiate among five bacterial strains within a detection range spanning from 10 to 103 CFU/mL to 10 to 107 CFU/mL. Its practicality is further validated through the accurate identification of blind bacterial samples.
The rapid and accurate identification of various bacterial strains is of paramount importance for effective disease control, treatment, and prevention, and for ensuring the safety and quality of food products and the environment. While traditional bacterial recognition methods have been established as reliable, these methods are encumbered by limitations such as prolonged culture periods, the need for advanced analytical equipment, the demand for specialized technical expertise, and location-specific restrictions which impede their broad application.
What Makes the New Bacterial Discrimination Method Unique?
Fluorescence analysis technology, known for its high sensitivity, specificity, and accuracy, is employed extensively in sensor development. Current research in bacterial detection via fluorescence sensors focuses primarily on the unique interactions between the sensor and bacteria leading to fluorescence quenching. The recognition elements include antimicrobial peptides, antibodies, bacteriophages, and aptamers. Furthermore, the selection of fluorescent moieties is crucial for sensor sensitivity.
Fluorescent nanomaterials characterized by their high quantum yield, exceptional stability, and prolonged fluorescence lifetime are widely utilized in crafting sensors. Notably, carbon quantum dots (CQDs), a type of zero-dimensional carbon nanomaterial smaller than 10 nm, are valued for their straightforward synthesis, stable fluorescence, and minimal cytotoxicity, making them promising candidates for fluorescent sensing applications.
How Does the New Bacterial Discrimination Method Improve Upon Traditional Methods?
The diminutive size and potent adsorption properties of CQDs facilitate their enhanced accumulation on bacterial surfaces, leading to more distinct fluorescence labeling. CQDs can also be engineered in various colors to detect different bacterial types. Nevertheless, despite the specificity afforded by traditional lock-and-key mechanism sensors, they struggle to detect multiple analytes simultaneously and are susceptible to interference from structurally similar substances.
Sensor arrays, characterized by their high-throughput capabilities, serve as efficient tools for the simultaneous detection and identification of diverse analytes. Unlike traditional sensors that demand high specificity, these arrays utilize a variety of nonspecific sensing elements that mimic mammalian taste and olfactory systems. These elements generate a broad range of responses, collectively forming distinct patterns that aid in the recognition of multiple analytes.
What is the Future of Bacterial Discrimination?
A key advantage of sensor arrays lies in their ability to address the challenges associated with the development of specific recognition receptors, offering significant benefits such as the recognition of a wide array of targets, robust interference resistance, concurrent detection capabilities, and the ability to differentiate between targets with similar structures or features.
Recent research has demonstrated that the integration of machine learning (ML) techniques, including linear discriminant analysis, decision trees, and k-nearest neighbors, into sensor arrays can significantly improve the accuracy of pattern recognition in analyte detection. Various sensor arrays employing distinct recognition mechanisms have been developed for bacterial detection, leveraging differences in bacterial volatile compounds, metabolite, and surface electron negativity.
Nonetheless, there are certain limitations in the current design of sensor arrays for bacterial differentiation, especially in the fabrication of sensing elements and the portability of platforms. This underscores the urgent need to develop simple, portable, and rapid bacterial discrimination methods. With its cost-effectiveness, ease of fabrication, and a high degree of integration, the new platform holds significant promise for the on-site detection of diverse bacteria.
Publication Date: 2024-04-17
Authors: Fangbin Wang, Minghui Xiao, Ji Qi, Liang Zhu, et al.
Source: Analytical and bioanalytical chemistry/Analytical & bioanalytical chemistry
DOI: https://doi.org/10.1007/s00216-024-05262-4